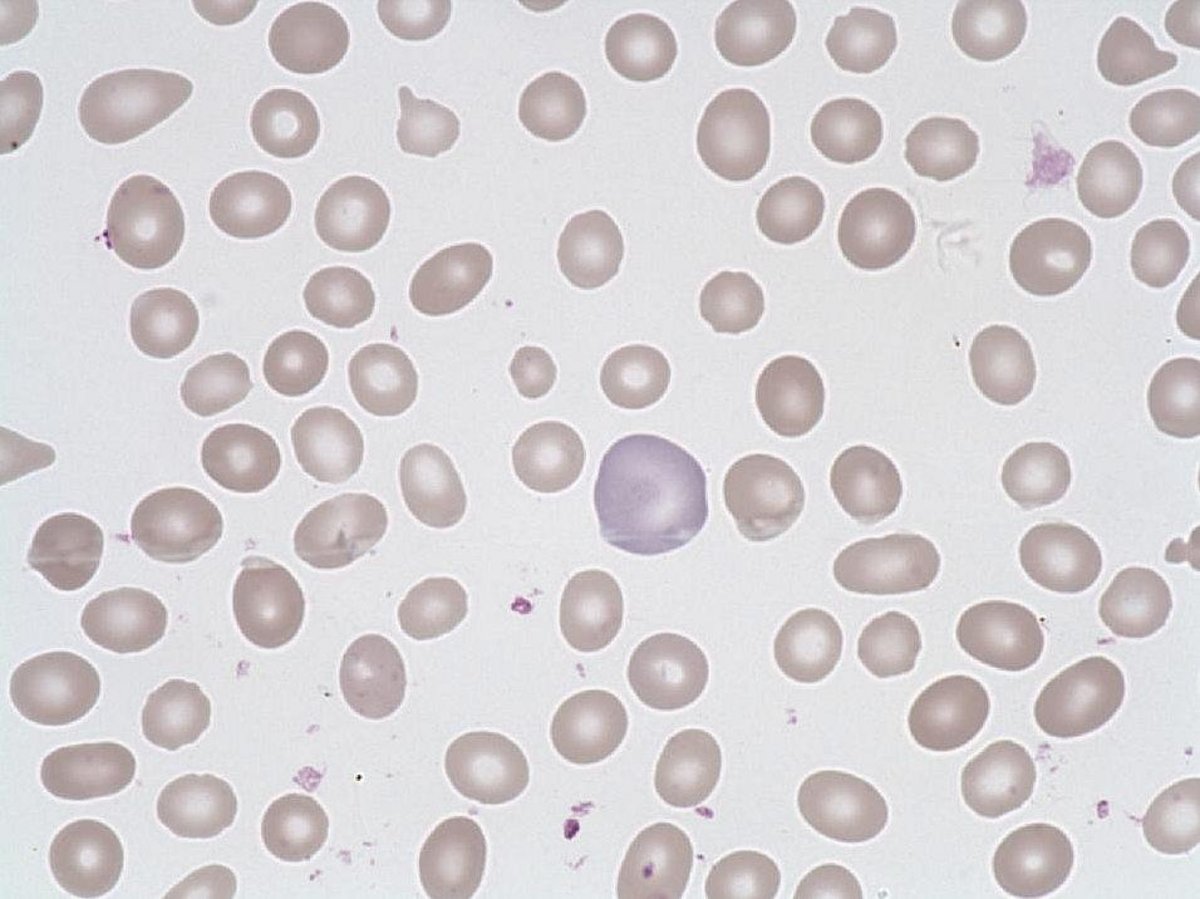
Polychromatophil

Polychromatophil
- Size : > 1 RBC
- Normal values : Rare in the blood
- Description / Pathology :
Red blood cells of various bluish purple tinge. It may correspond to the presence of reticulocytes.
Regenerative anemia, dyserythropoiesis.
Red blood cells of various bluish purple tinge. It may correspond to the presence of reticulocytes.
Regenerative anemia, dyserythropoiesis.